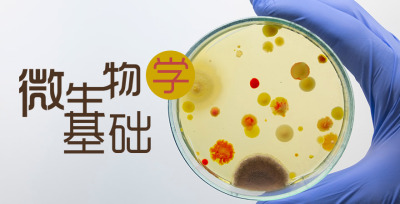

-
- 智慧树在线客服
- 服务时间:8:30-24:00
-
- 400-829-3579
- 服务时间:8:30-24:00
-
- 帮助
微生物学基础课程,是探索生命奥秘的绝佳途径。通过此课程引领同学们走进微观世界,领略微生物的神奇魅力。课程内容丰富,涵盖微生物的分类、生理、遗传、生态等多个方面,通过生动的实验和案例分析,帮助学生深入了解微生物的特性和应用。快加入我们微生物学的大家庭,一起探索微小世界的神奇之处。
累计选课
人
选课学校
所
公众学习者所属学校
所
累计互动
次
了解更多
老师您好!感谢您对本课的认可,请准确填写您的个人信息,
我们的运行服务专员会跟您联系,沟通选课事宜。
提交成功
我们的运行服务专员会在1-3个工作日内同您进行电话沟通,请保持手机畅通
请选择您的使用目的
该门课程当前学期未运行哦~
如您是为了自我提升请选择下方【去学习】按钮;如无【去学习】按钮则说明老师并未发布该课程的公开课,请选择其他课程
您当前身份为学生,仅老师可提交共享课选课申请。
该门课程未发布公开课,请选择其他课程~
该门课程为资源库课程,请去学堂选择【资源库课程】~
您当前选中的课程